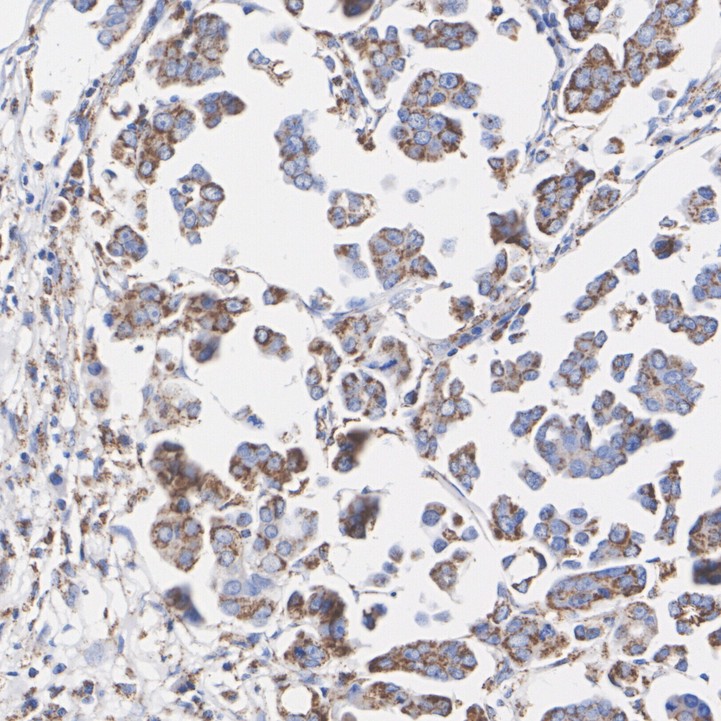

Total OXPHOS Antibody Cocktail Recombinant Rabbit Multiclonal Antibody [PSH15-50]


Catalog# HA723756
Total OXPHOS Antibody Cocktail Recombinant Rabbit Multiclonal Antibody [PSH15-50]
Application
-
WB
-
IHC-P
Reactivity
-
Human